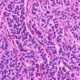
Tumores neuroendocrinos gastroenteropancreáticos

Los glucagonomas son tumores poco comunes que se originan en las células alfa del páncreas, que son responsables de producir la hormona glucagón. Estos tumores son neuroendocrinos y pueden ser clasificados como malignos, a pesar de que su aspecto histológico (la apariencia bajo el microscopio) a menudo puede ser benigno, lo que significa que no parecen tener características típicas de malignidad.
Aunque los glucagonomas son raros, son una de las variantes más comunes de los tumores neuroendocrinos pancreáticos. Suelen presentarse como tumores grandes dentro del páncreas, lo que puede dificultar su detección temprana. Aproximadamente el 60% de los casos ya presentan metástasis hepáticas (propagación del tumor al hígado) en el momento del diagnóstico, lo que sugiere que estos tumores tienen una tendencia a diseminarse a otras partes del cuerpo.
Una característica distintiva de los glucagonomas es que, además de producir glucagón, suelen secretar hormonas adicionales. Una de las hormonas más comúnmente producidas es la gastrina, que es una hormona involucrada en la estimulación de la producción de ácido gástrico en el estómago. La producción excesiva de gastrina puede llevar al desarrollo de úlceras pépticas en el estómago o el duodeno, lo que puede causar síntomas gastrointestinales como dolor abdominal, náuseas y vómitos.
Otros síntomas y manifestaciones asociadas con los glucagonomas pueden incluir pérdida de peso involuntaria, diarrea, anemia, erupciones cutáneas y niveles anormales de glucosa en sangre, como hiperglucemia (niveles elevados de azúcar en la sangre).
Debido a que los glucagonomas son tumores poco frecuentes y a menudo se diagnostican en etapas avanzadas, el pronóstico puede ser reservado. El tratamiento generalmente incluye una combinación de enfoques terapéuticos, que pueden incluir cirugía para extirpar el tumor, medicamentos para controlar los síntomas y reducir la producción hormonal, y en algunos casos, terapias dirigidas o quimioterapia para el control de las metástasis.
Es importante que los pacientes con glucagonomas sean tratados por un equipo médico multidisciplinario que incluya especialistas en oncología, endocrinología, cirugía y otras disciplinas, para proporcionar el mejor enfoque de tratamiento y seguimiento a cada paciente individual. Además, se alienta a los pacientes a participar en programas de seguimiento a largo plazo para detectar recurrencias o nuevas metástasis y abordar cualquier complicación que pueda surgir.

Fuente: Carvajal H, Carlos, Azabache C, Verónica, Lobos B, Pedro, & Ibarra V, Alvaro. (2002). Glucagonoma: Evolución y tratamiento. Revista médica de Chile, 130(6), 671-676.
Síguenos en X: @el_homomedicus y @enarm_intensivo Síguenos en instagram: homomedicus y en Treads.net como: Homomedicus